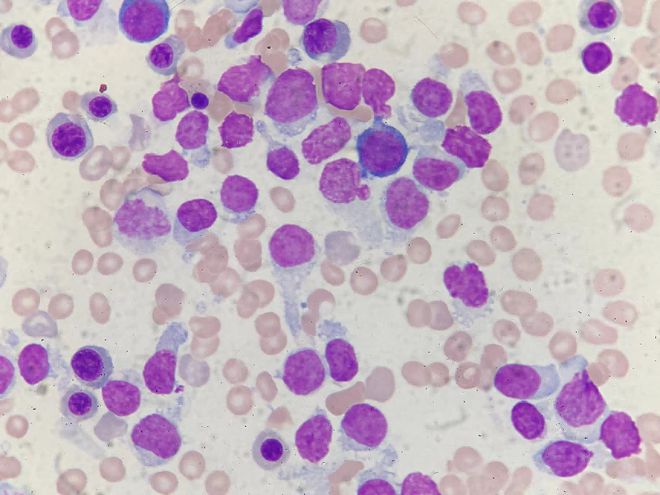
糖尿病患者如何补硒(糖尿病患者补硒有作用吗)-硒宝网

糖尿病患者如何补硒(糖尿病患者补硒有作用吗)
当今社会相信大家通过丰富的网络肯定会听说过硒,而大家只是听到说硒缺并没了解过硒,不明白硒的主要作用是什么,那么现在我就给大家普及一下硒的作用。
硒是我们身体非常重要的一种元素了,能够很好的?;じ卧?,对于增强身体的免疫力和预防心脑血管疾病是有非常重要的作用,我们的身体如果是出现了缺少硒元素,就是会对身体造成非常不利的影响,所以我们就是一定要注意在生活中补充硒元素,保证身体健康。
据了解当今社会我或人口平均每日摄入硒的含量为26毫克,世界卫生组织倡导大家每日摄取50~400毫克的硒元素,而硒只能摄取不能体内自动合成,所以大家每日应当每天多摄入一些含有硒元素的食品。

那么为什么说富硒姐姐富硒鸡蛋可以让大家告别糖尿病呢。最近的医学研究表明,糖尿病患者血液中的硒含量明显低于健zhi康人。在缺硒状态下,人体抗氧化系统的重要物质-谷胱甘肽过氧化物酶的活性降低,对自由基的清除能力减弱,脂质过氧化物增多,使胰岛受到过氧化损伤,其分泌胰岛素的功能随之减退。人体胰岛素缺乏,就出现糖代谢的紊乱,血糖水平升高,尿糖大量排出。

医学工作者研究的结论是:缺硒导致的胰岛过氧化损伤是糖尿病的诱因之一
补硒能激活谷胱甘肽过氧化物酶谷胱甘肽过氧化物酶专职催化谷胱甘肽与过氧化物的反应,使其还原成无害的物质,以?;せ迕馐芄趸鸷ΑN枪入赘孰墓趸锩傅幕钚灾行奈镏?,只有在人体硒含量充分的情况下,谷胱甘肽过氧化物酶才有活性,胰岛正是依仗充足的硒来改善自身的防御损伤系统。硒从氧化剂的角度?;ぷ乓鹊?。

补硒?;?、修复胰岛细胞

胰岛内分泌细胞( 60%-80%为β细胞)含大量的内质网,网膜是自由基攻击的主要目标。糖尿病患者胰岛素分泌不足,最直接的原因就是胰岛素的制造工厂——胰岛细胞受损或其功能没有完全发挥。补硒提高了血及胰腺谷胱甘肽过氧化物酶的活性,阻止这种攻击损害,保护了细胞的膜结构,使胰岛β细胞恢复、保持正常分泌与释放胰岛素的功能。营养、修复胰岛细胞,恢复胰岛功能,让其自行调控血糖才是治疗糖尿病的根本。
那么有人问到去哪里补硒呢,富硒姐姐富硒鸡蛋通过在鸡饲料中添加亚硒酸钠复合剂、含硒酵母和有机硒(如蛋氨酸,富硒鸡蛋是指含硒量为0.2~0.5mg/kg的鸡蛋。它可以为洋鸡蛋、杂交鸡蛋、土(硒)产生。富硒姐姐富硒鸡蛋的胆固醇相当于普通鸡蛋的2分之1,所以在补硒的同时又无需担心胆固醇过高。
每天只需两颗富硒鸡蛋让你远离糖尿病,享受健康生活。
